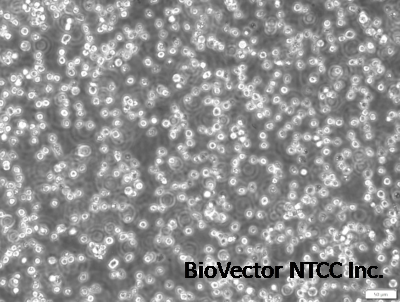
Nalm6-Fluc-Puro/CD19-KO - Imanis Life Sciences | United States

CD19 knockout Nalm6-luciferase NTCC®人B细胞前体急性淋巴细胞白血病细胞株cell line-BioVector NTCC细胞保藏中心
- 价 格:¥1998950
- 货 号:NTCC®CD19 knockout Nalm6-luciferase
- 产 地:北京
- BioVector NTCC典型培养物保藏中心
- 联系人:Dr.Xu, Biovector NTCC Inc.
电话:400-800-2947 工作微信:1843439339 (QQ同号)
邮件:Biovector@163.com
手机:18901268599
地址:北京
- 已注册
CD19 knockout Nalm6-luciferase NTCC®人B细胞前体急性淋巴细胞白血病细胞株human B-cell precursor acute lymphoblastic leukemia (ALL) cell line
BioVector NTCC质粒载体菌株细胞蛋白抗体基因保藏中心
The NTCC® CD19 knockout Nalm6-luciferase cell line is a valuable tool for research in immunology and oncology. Here's a breakdown of its key features and significance:
Key Features:
Nalm6 Origin: Derived from the Nalm6 cell line, a human B-cell precursor acute lymphoblastic leukemia (ALL) cell line.
CD19 Knockout: The CD19 gene, which encodes a protein essential for B-cell development and function, has been genetically removed using CRISPR/Cas9 technology.
Luciferase Expression: The cell line constitutively expresses firefly luciferase, allowing for non-invasive monitoring of cell growth and proliferation using bioluminescence imaging techniques.
Significance in Research:
Studying CD19 Function: The CD19 knockout enables researchers to investigate the role of CD19 in B-cell development, signaling pathways, and immune responses.
Cancer Research:
Modeling B-cell Malignancies: The cell line can serve as a model for B-cell malignancies, such as B-ALL, that express CD19.
Evaluating CD19-Targeted Therapies: The CD19 knockout can be used to assess the efficacy of CD19-targeted therapies, such as chimeric antigen receptor (CAR) T-cell therapies, which are revolutionizing cancer treatment.
Drug Discovery: The cell line can be used to screen for new drugs that target B-cell malignancies or modulate B-cell function.
Applications:
Immunology Research: Studying B-cell development, differentiation, and function.
Oncology Research: Investigating B-cell malignancies, evaluating CD19-targeted therapies, and screening for new anticancer drugs.
Drug Discovery: Identifying and developing novel therapeutic agents for B-cell-related diseases.
Note:
The use of this cell line requires appropriate safety measures in the laboratory, as it involves working with genetically modified organisms.
The characteristics and behavior of the CD19 knockout Nalm6-luciferase cell line can be influenced by various factors, such as culture conditions and the presence of other cells or factors in the environment.
Image

生产厂家Supplier:
BioVector NTCC质粒载体菌株细胞蛋白抗体基因保藏中心
E-mail:BioVector@163.com
http://www.biovector.net
- 公告/新闻




